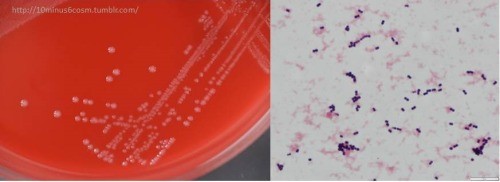

הדבקה בסטרפטוקוקוס מסוג בי - Group B Streptococcus infection
| מדריך בדיקות מעבדה | |
| הדבקה בסטרפטוקוקוס מסוג בי | |
|---|---|
| Group B Streptococcus infection | |
| שמות אחרים | GBS, Streptococcus agalactiae, Streptococcus agalactiae, Beta-Hemolytic Strep, Group B streptococcus. |
| 250 פיקסלים | |
β-hemolytic colonies of Streptococcus agalactiae, blood agar 18h at 36°C
| |
| מעבדה | מיקרוביולוגיה/בקטריולוגיה. |
| תחום | אבחון הדבקה בסטרפטוקוקוס group B בעיקר ביילודים ותינוקות או בנשים הרות. |
| יוצר הערך | פרופ' בן-עמי סלע |
מטרת הבדיקה
סריקה אחר מושבות של Streptococcus agalactiae בנשים הרות בשבוע ההיריון ה-36–37, כבדיקה מנחה לצורך של טיפול מניעתי אנטיביוטי במהלך הלידה, על מנת להפחית את הסיכון של הדבקת הילוד בחיידק זה.
Group B streptococcus (להלן GBS) הוא חיידק נקד (coccus) גראם-חיובי, עם נטייה ליצור שרשרות, הוא חיידק βnbhcu,-המוליטי, catalase negative, ואנארובי פקולטטיבי (Whiley ו-Hardie ב-Bergies Manual System Bacteriol משנת 2009, ו-Ryan ב-Sheriss Med Microbiol משנת 2004). החיידק S. agalactiae הוא הזן היחיד של חיידקי סטרפטוקוקוס השייך ל-group B על פי דירוג Rebecca Lancefield של חיידקים אלה. ה-GBS מוקף על ידי קפסולה המורכבת על ידי exopolysacchride. זן זה מתחלק לעשרה serotypes (Ib, Ia, ו- II-IX) התלויים בפעילות האימונולוגית של הקפסולה הפוליסכרידית שלהם (Slotved וחב' ב-J Clin Microbiol משנת 2007). כללית, GBS הוא חיידק קומנסלי שאינו מזיק ומהווה חלק של המיקרוביוטה המאכלסת את מערכת העיכול ואת המערכת ה-genitourinary של 30% מהמבוגרים הבריאים שם בהחלט א-תסמיניים לנוכחות חיידק זה. למרות זאת, החיידק עלול לגרום לזיהומים קשים בעיקר ביילודים, קשישים או באלה עם מערכת חיסון פגועה (Edwards ו-Baker ב-Principles Practice Infect Dis משנת 2010). S. agalactiae הוא גם פתוגן וטרינרי שכיח הגורם לדלקת העטין (mastitis) בפרות מניבות חלב.
זיהוי מעבדתי
GBS גדל בקלות על פלטות אגר-דם כאשר המושבות מוקפות באזור צר של β-hemolysis. החיידק GBS מאופיין על ידי דופן המכיל את האנטיגן group B (על פי הדירוג של Lancefield) שניתן לזהות ישירות בחיידקים שלמים על ידי מבחני צימות של חלקיקים מצופים ב-latex (Tille ב-Bailey & Scott's Diagnostic Microbiology 13ed משנת 2014, ו-Rosa-Fraile ו-Spellerberg ב-J Clin Microbiol משנת 2014). מבחן CAMP הוא עזר חשוב נוסף לזיהוי GBS. תוצאות מבחן יכולות להתקבל תוך 18 שעות, והוא מתבצע על אגר-דם של כבש או בקר, ונותן רק לעיתים רחוקות תשובה false positive עם סטרפטוקוקים אחרים. ממצא המוליטי זה תואר לראשונה בשנת 1944 על ידי Atkins ,Chrstie ו-Munch-Petersen ונושא את שמותיהם. GBS מסוגל גם לבצע הידרוליזה של hippurate, מה שמהווה אמצעי נוסף לזיהוי GBS. זנים המוליטיים של GBS מייצרים צבען כתום של ornithine rhamnolipid שלnon-isoprenoid polyene הידוע כ-granadaene (To וחב' ב-BMC Res משנת 2019).
ניתן לזהות GBS ב-mass spectrometry בשיטת MALDI-TOF (או Matrix Assisted Laser Desorption/Ionization-Time of Flight (על פי Filkins וחב' ב-Am Soc Microbiol משנת 2020). מושבות של GBS יכולות להיות מזוהות על פי הופעתן במדיום של אגר כרומוגני, ואף-על-פי-כן יש צורך לאשש אותן כמושבות GBS תוך שימוש במבדקים אמינים נוספים כגון אגלוטינציה של חלקיקי latex, או במבחן CAMP למנוע זיהוי שגוי (Barcaite וחב' ב-Acta Obstet Gynecol Scand משנת 2008, ו-Pignanelli וחב' ב-Indian J Pathol Microbiol משנת 2015). סיכום של שיטות המעבדה לזיהוי של GBS ניתן למצוא ב-Roas-Fraile וחב' ב-J Clin Microbiol משנת 1999).
מושבות של GBS
חיידקי GBS הם מרכיבים נורמליים של המיקרוביוטה של המעיים ושל הנרתיק בחלק מהנשים, וחיידק זה א-תסמיני במערכת העיכול ובנרתיק של עד 30% מהמבוגרים הבריאים, כולל נשים הרות (Russell וחב' ב-Clin Infect Dis משנת 2017). מושבות GBS יכולות להימצא באופן קבוע או זמני במעיים. על פי מחקרים אחדים, השיעור של מושבות GBS נע בין 0-36%, אם כי רוב המחקרים מצביעים על שיעור של 20% של מושבות אלו בנרתיק בנשים פעילות מינית (Rodriguez-Granger וחב' ב-Eur Clin Microbiol Infect Dis משנת 2012). על פי הערכה השיעור של מושבות GBS באמהות בעולם הוא כ-18%, עם הבדלים אזוריים שנעים בין 11-35% (Rajagopal ב-Future Microbiol משנת 2009), אך הבדלים אלה בשיעורי GBS א-תסמיני ניתנים לייחוס לשיטות הזיהוי של החיידק ולהבדלים באורח ובתנאי החיים (Armistead וחב' ב-J Mol Biol משנת 2019).
אלימות החיידק
כמו כל החיידקים האלימים, ל-GBS יש מספר גורמי אלימות כגון הפוליסכריד הקפסולרי העשיר בחומצה סיאלית (Edwards ו-Nizet ב-Infect Dis Fetus Inborn Infant משנת 2011, ו-Armistead וחב' ב-Front Microbiol משנת 2020), וכן טוקסין מחוֹרר שהוא β-hemolysin (על פי Rosa-Fraile וחב' ב-FEMS Microbiol Rev משנת 2014, ו-Whidbey וחב' ב-J Exp Med משנת 2013). סבורים שהצבען והטוקסין של GBS הן מולקולות הכרוכות זו בזו (Whidbey וחב' ב-EMBO Mol Med משנת 2015, Puopolo וחב' ב-Pediatrics משנת 2019, Muller וחב' ב-Acta Obstet Gynecol Scand משנת 2006, ו-leclercq וחב' ב-Sci Rep משנת 2016).
הדבקה של GBS ביילודים
יצירת מושבות בדרך כלל אינה גורמת לבעיות בנשים בריאות, ואף-על-פי-כן במהלך היריון היא עלולה לגרום לחולי חמור באישה ההרה ובעוברה או ביילוד. GBS הוא הגורם המוביל להדבקה סב-לידתית ביילוד במהלך ההיריון ולאחר הלידה, עם שיעורי תמותה משמעותיים בפגים, הדבקות GBS בנשים הרות עלולות לגרום ל-chorioamnionitis שהיא הדבקה חמורה בשלייה באופן שאינו שכיח, הדבקות שלאחר הלידה, והן אף גורם מקובל ללידה טרם-עת ולתמותת עוברים ויילודים (Verani וחב' ב-MMWR Recomm Rep משנת 2010. הדבקות של GBS במערכת דרכי השתן (UTI) עלולות אף הן להקדים את הלידה ולהביא להולדת פגים. בעולם המערבי, GBS (בהיעדר אמצעי מניעה יעילים) הוא הגורם המוביל להדבקות חיידקיות אחדות, ולגרום לספסיס ביילוד, לדלקת ריאות ולמנינגיטיס שעלולות להיות קטלניות, או להשלכות בריאותיות בהמשך.
הדבקת יילודים ב-GBS מקורו באופן אופייני בחלק התחתון של מערכת הרבייה של האימהות הנגועות. הדבקות GBS ביילודים מתחלקות לשני תסמינים קליניים כאלה המופיעים מוקדם (EOD) וכאלה המופיעים מאוחר (LOD) (Edmond וחב' ב-Lancet משנת 2012, ו-Libster וחב' ב-Pediatrics מאותה שנה). תסמיני EOD יכולים להופיע מיום הלידה ועד 7 ימים לאחר הלידה, כאשר רובם מופיעים 24 שעות לאחר הלידה (Boyer ו-Gotoff ב-Antibiotics & Chemotherapy משנת 1985). התסמינים השכיחים ביותר של EOD הם ספסיס ודלקת ריאות ובשכיחות נמוכה יותר מניניגיטיס. EOD מועבר מהאם ליילודה ורטיקלית, כתוצאה מחשיפת העובר/יילוד למושבות GBS בנרתיק עוד בהיותם ברחם או במהלך הלידה. בערך 50% מהיילודים של אימהות עם מושבות GBS מתגלים בדיעבד כבעלי מושבות אלו, אם כי רק 1-2% מתוכם ייפתחו תסמיני EOD (Nanduri וחב' ב-JAMA Pediatr משנת 2019). בשנת 2008 ולאחר השימוש הנרחב של סריקה קדם-לידתית ושל טיפול אנטיביוטי פרופילקטי במהלך הלידה (IAP), דיווח ה-CDC על שכיחות של 0.28 מקרים של EOD לכל אלף לידות-חי בארצות הברית (Russell וחב' ב-Clin Infect Dis משנת 2017). סקר בין-מדינתי בין השנים 2006–2015 מצביע על דעיכה ב-EOD מ-0.37 ל-0.23 מקרים לכל 1,000 לידות חי בארצות הברית, אך השכיחות של LOD נותרה יציבה (0.31 מקרים לכל 1,000 לידות חי ) על פי Nanduri וחב' ב-JAMA Pediatr משנת 2019.
אף על פי שמושבות GBS אימהיות הן גורם המפתח ל-EOD, גורמים אחרים מגבירים אף הם את הסיכון. גורמים אלה כוללים התחלת לידה טרם זמנה (מהשבוע ה-37 להיריון), פקיעה ממושכת של שק מי השפיר (למעלה מ-18 שעות לפני הלידה), חום של מעל 38 מעלות במהלך הלידה, הדבקות של שק מי השפיר (chorioamnionitis), גיל צעיר של היולדות, ורמה נמוכה של נוגדנים ביולדת כנגד פוליסכרידים קפסולריים של GBS. אף-על-פי-כן רוב התינוקות המפתחים EOD נולדים לאימהות נגועות במושבות GBS ללא גורם סיכון נוסף. אחאי/ת קודמים במשפחה עם EOD גם הוא גורם סיכון להתפתחות זיהום בלידות הבאות, מה שמשקף כנראה חסר בנוגדנים המגינים כנגד פוליסכרידים של GBS באם היולדת. ריבוי של מושבות GBS בנרתיק אף הוא כרוך בסיכון מוגבר ל-EOD. בסך הכול, מקרי המוות מ-EOD דעכו מ-50% מהמקרים בשנות ה-70 של המאה ה-20 ל-2-10%, בעיקר כתוצאה משיפור בתרפיה ובהתנהלות. מקרי מוות מזיהומי GBS ביילודים פגים הם עדיין שכיחים יותר (Kohli-Lynch וחב' ב-Clin Infect Dis משנת 2017).
התסמינים המאוחרים יותר של הדבקה ב-GBS (LOD), באים לביטוי בתינוקות בגיל 7 ימים עד 3 חודשים, והם יותר צפויים לגרום לבקטרמיה או למנינגיטיס. LOD עלול להיגרם כתוצאה מהדבקה מהאם או ממקורות חיצוניים. איבוד שמיעה או פגיעה מנטלית עלולים להיות תופעות ארוכות טווח של מנינגיטיס מ-GBS (Baker ב-Vaccine משנת 2013, ו-Huges וחב' ב-Br J Obstet Gynecol משנת 2017). בניגוד ל-EOD, ההתרחשות של LOD נותרה יציבה עם 0.26 מקרים לכל 1,000 לידות-חי בארצות הברית (Clifford וחב' ב-J Pediatr Child Health משנת 2011). מנינגיטיס סב-לידתית מ-S. agalactiae אינו דומה לתסמין הבולט של מנינגיטיס במבוגרים שהוא צוואר קשוח. במקום זאת, יש מספר תסמינים לא-ספציפיים כמו חום מוגבר, הקאות ורגזנות, מה שעלול לעכב את אבחון התרחיש.
הדבקות GBS במבוגרים
GBS הוא גם גורם הדבקות חשוב המסוגל לגרום לזיהומים חודרניים במבוגרים. בקשישים ובאלה הסובלים ממחלות כסוכרת, שחמת הכבד וסרטן, זיהום חודרני של GBS עלול לסכן חיים (Farley ב-Clin Infect Dis משנת 2001). זיהומי GBA במבוגרים עלולים להופיע בדרכי השתן, בעור וברקמות רכות ולגרום לבקטרמיה, לאוסטאו-מייאליטיס, מנינגיטיס ואנדוקרדיטיס. בדרך כלל פניצילין היא האנטיביוטיקה המומלצת לטיפול בהדבקות וזיהומי GBS, אך גם גנטמיצין יכול לשמש למטרה זו.
מניעת הדבקות סב-לידתיות
השיטה האמינה היחידה למניעת EOD היא טיפול אנטיביוטי פרופילקטי במהלך הלידה (IAP). נמצא שעירוי ורידי של פניצילין או אמפיצילין הניתן לפחות 4 שעות לפני הלידה, לנשים הידועות כנושאות מושבות של GBS, יעיל מאוד למנוע העברה אנכית של GBS מהאם ליילוד במהלך הלידה, ולמנוע EOD. פניצילין תוך-ורידי נותר תכשיר הברירה לטיפול מניעתי. כאשר אמפיצילין מהווה טיפול קו-שני. בנשים אלרגיות לפניצילין, תכשירים חלופיים הם cefazoline או clindamycin, וכן vancomycin למניעת EOD ביילודים, מתן ורידי של vancomycin מומלץ כאמצעי למניעת EOD ביילודים אם האם עמידה ל-clindamycin או מאוד אלרגיות לפניצילין. ישנן שתי דרכים לזהות נשים מועמדות לטיפול מניעתי אנטיביוטי במהלך הלידה: הגישה המבוססת על תרבית לזיהוי מועמדות לטיפול אנטיביוטי. נוטלת דגימות מהנרתיק ומהחלחולת בין שבועות 36–37 להיריון, או בין 32–34 שבועות בהיריון של תאומים (Yancey וחב' ב-Obstet Gynecol משנת 1996). הגישה המבוססת על דרגת הסיכון של האישה להיות מודבקת ב-GBS, מתייחסת להסתברות של EOD, בלי להתחשב בכך שהאישה אמנם נושאת חיידקי GBS (Le Doare וחב' ב- Clin Infect Dis משנת 2017).
IAP מומלץ גם בנשים גם אם סטאטוס ההדבקה ב-GBS אינו ידוע בעת הלידה, אך הן מאובחנות עם חיידקי GBS בשתן מהלך ההיריון, או בנשים שכבר ילדו בעברן תינוק עם EOD. הגישה המבוססת על סיכון פחות יעילה מהגישה המבוססת על תרבית, שכן ברוב המקרים ה-EOD אובחן בתינוקות שנולדו לאימהות ללא גורמי סיכון. הגישה המתבססת על תרבית נקוטה ברוב המדינות המפותחות פרט לארצות הברית (Cortés וחב' ב-Rev Esp Quimioter משנת 2012), כמו צרפת, ספרד, בלגיה קנדה וארגנטינה ואוסטרליה (Trijbels-Smeulders וחב' ב-Arch Dis Child משנת 2007). הגישה של הסתמכות על גורמי סיכון נהוגה עדיין בבריטניה (Valkenburg-van-den-Berg וחב' ב-Gynecol Obstet משנת 2010) ובהולנד (Virranniemi וחב' ב-Acta Obstet Gynecol Scand משנת 2019).
איתור של מושבות GBS
אף על פי שסטאטוס המושבות של GBS יכול להשתנות במהלך היריון, תרביות לזיהוי GBS שבוצעו פחות מ-5 שבועות לפני הלידה, מנבאות בצורה יחסית מדויקת את סטאטוס ההידבקות ב-GBS במהלך הלידה. לעומת זאת, אם תרבית קדם-לידתית מבוצעת למעלה מ-5 שבועות לפני הלידה, תוצאותיה אינן אמינות לצורך ניבוי מדויק של סטאטוס הנשאוּת של GBS במהלך הלידה (Jordan וחב' ב-Pediatr Infect Dis J משנת 2008). הדגימות הקליניות המומלצות לביצוע התרבית בשבוע ה-36–37 להיריון, הם מטושים הנוטלים חומר מחלק הנרתיק התחתון (סמוך ל-introitus), ואז נטילת חומר מהחלחולת (ללא שימוש ב-speculum). על פי המלצת ה-CDC החומר הנאסף במטוש צריך להיטבל במרק העשרה הידוע כ-Todd Hewitt broth עם חומר אנטיביוטי (Edewads וחב' ב-Emerg Infect Dis משנת 2016). לאחר הדגרה מרק העשרה זה מועבר לפלטות של אגר-דם, ומושבות של GBS מזוהות על ידי מבדק CAMP, או על ידי ביצוע אגלוטינציה של חלקיקי latex עם אנטי-סרום כנגד GBS. לאחר הדגרה, ניתן להעביר את מרק ההעשרה גם לאגר Granada, בו GBS גדל כמושבות אדומות.
פותחו מבחני אמפליפיקציה של חומצות גרעין (NAAT) כגון PCR ו-DNA hybridization, לזיהוי ישיר של GBS מדגימות רקטו-וגינליות, אך אלה עדיין אינם מסוגלים לבוא במקום נשאוּת של GBS באופן מדויק. אף על פי ש-IAP למניעת EOD כרוך בירידה גדולה בהתרחשות מחלה, אין לעומת זאת אסטרטגיה יעילה למניעת מחלת late-onset של מחלה הנגרמת מ-GBS. חיסון נחשב פתרון אידיאלי לא רק למנוע את EOD ו-LOD אלא גם למנוע הדבקות עם GBS במבוגרים הנמצאים בסיכון (davies וחב' ב-Pediatr Infect Dis J משנת 2019). אף-על-פי-כן, למרות מספר מחקרים וניסויים קליניים לפיתוח חיסון יעיל למניעת הדבקות ב-GBS, עד שנת 2020 לא היה מוכן חיסון כזה (Carreras-Abad וחב' ב-Infect Drug Resist משנת 2020, Edwards ו-Gonik ב-Vaccine משנת 2013, ו-Baker וחב' ב-J Infect Dis משנת 2014). הפוליסכריד הקפסולרי של GBS אינו רק גורם אלימות יעיל של החיידק, אלא גם מועמד מעולה לפיתוח החיסון המבוקש (Madhi וחב' ב-Lancet Infect Dis משנת 2016, Song וחב' ב-Hum Vaccin Immunother משנת 2018, ו-Graux וחב' ב-Eur J Clin Microbiol Infect Dis משנת 2020). מתקיים גם פיתוח של חיסונים מבוססים על אנטיגנים חלבוניים של GBS (על פי Edwards ו-Baker ב-Clin Infect Dis משנת 2005).
הוראות לביצוע הבדיקה
יש לשלוח למעבדה מטוש עשוי מ-Dacron או rayon, הנלקח מהנרתיק וכן מהחלחולת בהתאם להנחיות ACOG. מטוש הלקח רק מהנרתיק או רק מהחלחולת, לא יתקבל לבדיקה. המטוש חייב להיות טבול במדיום העברה למעבדה (Stuart or Amies liquid medium). מטוש יבש ייפסל לבדיקה. המטוש חייב להגיע למעבדה תוך 24 שעות מנטילתו (עדיף בטמפרטורת החדר אך ניתן גם בקירור). על פי תוצאת הבדיקה בתרבית על פלטות אגר, ייקבע אם יש צורך בבדיקות-המשך (reflex), כמפורט להלן:
| Test ID | Reporting Name |
|---|---|
| RMALD | Ident by MALDI-TOF mass spec |
| GID | Bacteria Identification |
| STRP | Identification Streptococcus |
| ISAE | Aerobe Ident by Sequencing |
| SIDC | Ident Serologic Agglut Method 4 |
ראו גם
- חזרה לדף מדריך בדיקות מעבדה
- בדיקות מעבדה - מחלות בקטריאליות/ זיהום בקטריאלי-אלח-דם
- בדיקות מעבדה - סמני דלקת
המידע שבדף זה נכתב על ידי פרופ' בן-עמי סלע, המכון לכימיה פתולוגית, מרכז רפואי שיבא, תל-שומר;
החוג לגנטיקה מולקולארית וביוכימיה, פקולטה לרפואה, אוניברסיטת תל-אביב (יוצר הערך)


 כניסה
כניסה  עקבו אחרינו בפייסבוק
עקבו אחרינו בפייסבוק